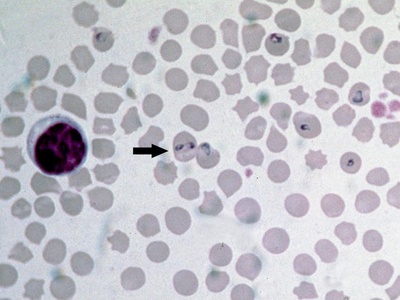
Babesia

From a drop of pond water to coastal plankton samples, microscopic life is everywhere and continually shapes local ecosystems. This list gathers species you might encounter when sampling freshwater and marine environments, helping you spot patterns in communities and habitats.
There are 44 Protists, ranging from -green algal filament to Vorticella. The entries are organized with Scientific name,Habitat,Size (µm) so you can compare taxa side by side, and you’ll find below.
How can I use this list to help identify protists in a water sample?
Start by noting where the sample came from and the approximate cell size under a microscope; match those to the Habitat and Size (µm) columns here. Look for distinctive shapes or movement, then check the Scientific name entries for images or references; many protists require higher magnification or staining for confident ID.
Why do Habitat and Size (µm) matter when comparing these organisms?
Habitat narrows the likely candidates—some protists prefer benthic biofilms, others planktonic zones—while size affects what predators and prey they interact with and which microscopy methods reveal them. Together those columns make the list useful for ecological interpretation and practical identification.
Protists
| Name | Scientific name | Habitat | Size (µm) |
|---|---|---|---|
| Amoeba | Amoeba proteus | freshwater | 200–800 |
| Entamoeba (pathogen) | Entamoeba histolytica | host | 10–60 |
| Foraminifera | Ammonia beccarii | marine | 100–1,000 |
| Radiolarian | Acantharea (Radiolaria) | marine | 50–500 |
| Diatom | Navicula | freshwater and marine | 2–200 |
| Dinoflagellate | Alexandrium | marine | 20–200 |
| Euglena | Euglena gracilis | freshwater | 35–60 |
| Giardia | Giardia lamblia | host | 8–20 |
| Trypanosome | Trypanosoma brucei | host | 14–40 |
| Leishmania | Leishmania donovani | host | 2–20 |
| Malaria parasite | Plasmodium falciparum | host | 1–5 |
| Toxoplasma | Toxoplasma gondii | host | 4–8 |
| Cryptosporidium | Cryptosporidium parvum | host | 4–6 |
| Ciliate (Paramecium) | Paramecium caudatum | freshwater | 200–300 |
| Stentor | Stentor coeruleus | freshwater | 100–2,000 |
| Vorticella | Vorticella spp. | freshwater | 50–200 |
| Choanoflagellate | Monosiga brevicollis | marine and freshwater | 3–10 |
| Slime mold (plasmodial) | Physarum polycephalum | soil | 10–100 |
| Oomycete (water mold) | Phytophthora infestans | soil and host | 5–50 |
| Brown alga (kelp) | Macrocystis pyrifera | marine | 100–500 (cells) |
| Green alga (unicellular) | Chlamydomonas reinhardtii | freshwater | 10–15 |
| Volvox | Volvox aureus | freshwater | 500–50,000 |
| Sea lettuce (green alga) | Ulva lactuca | marine intertidal | 10–50 (cells) |
| Coccolithophore | Emiliania huxleyi | marine | 3–20 |
| Cryptophyte | Cryptomonas sp. | freshwater and marine | 10–30 |
| Brain-eating amoeba | Naegleria fowleri | freshwater | 10–35 |
| Acanthamoeba | Acanthamoeba castellanii | soil and freshwater and host | 15–35 |
| Bioluminescent dinoflagellate | Noctiluca scintillans | marine | 200–2,000 |
| Desmid | Closterium | freshwater | 30–300 |
| Babesia | Babesia microti | host | 1–3 |
| Perkinsus | Perkinsus marinus | marine host | 2–8 |
| Tetrahymena | Tetrahymena thermophila | freshwater | 50–60 |
| Oxyrrhis | Oxyrrhis marina | marine | 10–20 |
| Centric diatom | Coscinodiscus spp. | marine | 50–500 |
| Heliozoan | Actinophrys sp. | freshwater | 20–150 |
| Heterotrophic flagellate | Bodo saltans | freshwater | 3–6 |
| Silicoflagellate | Dictyocha speculum | marine | 10–40 |
| Blastocystis | Blastocystis hominis | host | 5–20 |
| Karenia (red tide) | Karenia brevis | marine | 10–40 |
| Mixotrophic chrysophyte | Mallomonas spp. | freshwater | 5–30 |
| Choanoflagellate colony | Salpingoeca sp. | marine | 5–50 |
| Apicomplexan (oyster parasite) | Perkinsus olseni | marine host | 2–10 |
| -green algal filament | Spirogyra | freshwater | 10–100 (cells) |
| Foraminiferal plankton | Globigerina bulloides | marine | 100–800 |
Images and Descriptions

Amoeba
Amoeba proteus is a familiar freshwater single-celled protist that crawls using pseudopods to engulf prey. Found in ponds and puddles, it’s easy to see under a microscope and is often used to demonstrate basic cell movement and feeding.

Entamoeba (pathogen)
Entamoeba histolytica is a parasitic protist that infects human intestines, causing amoebic dysentery. Transmitted via contaminated water or food, it’s medically important and widely studied for its invasive behavior and public health impact in tropical regions.

Foraminifera
Foraminifera are shelled, mostly marine protists found in sediments and open water. Their calcium carbonate tests preserve in sediments, making them vital to paleoclimate and paleoceanography studies and useful indicators of past and present marine environments.

Radiolarian
Radiolarians are intricate, silica-shelled planktonic protists common in oceans. Their ornate skeletons sink to become siliceous sediments; scientists use them to study ocean ecology and past ocean conditions, and they’re notable for their radial symmetry and spiny forms.

Diatom
Diatoms are photosynthetic protists with glassy silica cell walls that form beautiful ornate shapes. They thrive in freshwater and marine environments, drive much global primary production, and their silica frustules are important in sediment records and water quality studies.

Dinoflagellate
Dinoflagellates are diverse single-celled protists, some photosynthetic and some predatory. Genera like Alexandrium cause harmful algal blooms and shellfish poisoning. They’re ecologically important as primary producers and notable for bioluminescence and complex life cycles.

Euglena
Euglena gracilis is a flexible freshwater protist that combines photosynthesis with heterotrophy. It swims with a flagellum, has an eye-spot for light sensing, and illustrates how some protists blur lines between plant-like and animal-like lifestyles.

Giardia
Giardia lamblia is a flagellated intestinal protist that causes giardiasis, a diarrheal disease from contaminated water. Its distinctive two-nuclei trophozoite is easy to identify microscopically, and it’s a well-known public health concern in poor sanitation settings.

Trypanosome
Trypanosoma brucei is a blood-borne protist transmitted by tsetse flies, causing African sleeping sickness. Its elongated, flagellated form evades immune responses by changing surface proteins, making it a textbook example of parasite adaptation and medical importance.

Leishmania
Leishmania spp. are intracellular protists transmitted by sandfly bites that infect macrophages and cause cutaneous or visceral leishmaniasis. Their life cycle alternates between flagellated promastigotes in vectors and non-motile amastigotes in vertebrate hosts.

Malaria parasite
Plasmodium falciparum is the most dangerous malaria-causing protist, infecting red blood cells and transmitted by Anopheles mosquitoes. Tiny in size, it’s globally significant for human health and has complex life stages that challenge vaccine and drug development.

Toxoplasma
Toxoplasma gondii infects many warm-blooded animals and can form long-lived tissue cysts; cats are the definitive host. Often asymptomatic, it’s notable for its global prevalence and effects on immunocompromised people and prenatal infection risks.

Cryptosporidium
Cryptosporidium parvum is a protozoan parasite causing watery diarrhea, often from contaminated water. Its hardy oocysts survive chlorine treatments, making it a concern for water safety and public health outbreaks in human and animal populations.

Ciliate (Paramecium)
Paramecium caudatum is a slipper-shaped freshwater ciliate covered in cilia used for swimming and feeding. Easy to observe, it feeds on bacteria, exhibits complex cellular structures like oral grooves, and is a classic classroom example of unicellular complexity.

Stentor
Stentor is a trumpet-shaped freshwater ciliate often attached to substrates. Some species grow very large for single cells and regenerate after damage, making them fascinating for studies of cell biology, regeneration, and feeding behavior in ponds.

Vorticella
Vorticella are stalked, bell-shaped ciliates that attach to surfaces in freshwater. Their contractile stalks and feeding cilia create water currents to capture bacteria, and they’re notable for their rapid stalk contraction and striking appearance under microscopes.

Choanoflagellate
Choanoflagellates are small flagellates with a collar of microvilli that capture bacteria; they are the closest single-celled relatives of animals. Found in marine and freshwater habitats, they’re studied for insights into the origins of multicellularity.

Slime mold (plasmodial)
Physarum polycephalum is a giant, multinucleate plasmodial protist found on moist forest floors. It explores with streaming veins to find food, can solve mazes experimentally, and fascinates scientists studying decentralized decision-making and movement.

Oomycete (water mold)
Phytophthora infestans is an oomycete plant pathogen famed for late blight in potatoes. Although fungus-like, it’s a stramenopile protist; its devastating crop impacts shaped history and continue to drive disease management research.

Brown alga (kelp)
Macrocystis pyrifera is a giant brown algal kelp forming underwater forests. While the whole thallus can be meters long, its cellular structures are microscopic. Kelp forests provide habitat and drive coastal productivity and carbon cycling.

Green alga (unicellular)
Chlamydomonas is a single-celled green alga used as a model organism for photosynthesis, flagellar movement, and cell biology. It swims with two flagella, senses light with an eyespot, and thrives in ponds and lab cultures.

Volvox
Volvox forms spherical colonies of many flagellated cells that cooperate, illustrating a simple step toward multicellularity. Colonies range from microscopic to visible sizes, live in freshwater, and are studied for evolution of cellular specialization and reproduction.

Sea lettuce (green alga)
Ulva lactuca is a common sheet-like green alga in intertidal zones. Its multicellular thallus is composed of microscopic cells; it’s ecologically important in coastal ecosystems and can form blooms in nutrient-rich waters.

Coccolithophore
Emiliania huxleyi is a tiny marine phytoplankton that builds calcium carbonate plates (coccoliths). Massive blooms can be seen from space; they influence carbon cycling, ocean optics, and form important components of marine sediments.

Cryptophyte
Cryptomonads are small flagellates with plastids and phycobiliproteins, common in fresh and coastal waters. They’re ecologically important as primary producers and prey, notable for cryptic plastid origins and mixotrophic lifestyles in diverse environments.

Brain-eating amoeba
Naegleria fowleri is a free-living amoeboflagellate found in warm freshwater. Rarely, it invades the brain through the nasal passages causing fatal infections. It’s infamous for its aggressive pathology and public concern around warm-water recreation.

Acanthamoeba
Acanthamoeba are common soil and freshwater amoebae that can opportunistically infect eyes and the brain, causing keratitis or encephalitis. They form resistant cysts and are studied for environmental resilience and clinical treatment challenges.

Bioluminescent dinoflagellate
Noctiluca scintillans is a large dinoflagellate that forms glowing nighttime blooms in coastal waters. Easily seen with the naked eye when abundant, these blooms can affect food webs and sometimes cause oxygen depletion in affected bays.

Desmid
Desmids are elegant, often symmetrical green algal protists found in clean freshwater. Their distinctive shapes and chloroplasts make them favorites for microscopy and indicators of water quality and oligotrophic conditions in peat bogs and lakes.
Babesia
Babesia microti is a tiny tick-transmitted protist that infects red blood cells in mammals, causing babesiosis. Symptoms can mimic malaria; it’s medically important in temperate regions and highlights the diversity of blood-borne protist parasites beyond Plasmodium.

Perkinsus
Perkinsus marinus is a protist parasite that infects oysters and other bivalves, causing disease and economic losses in aquaculture. Found in marine waters, it’s studied for host-pathogen interactions and impacts on shellfish populations.

Tetrahymena
Tetrahymena is a model freshwater ciliate used in research on genetics, cell biology, and molecular processes. It feeds on bacteria, reproduces rapidly, and its easy culturing makes it a staple in labs and teaching demonstrations worldwide.

Oxyrrhis
Oxyrrhis marina is a heterotrophic dinoflagellate common in coastal waters, feeding on other protists and bacteria. Its versatile feeding strategies and ecological role as a grazer make it a useful model for studying plankton dynamics and food webs.

Centric diatom
Coscinodiscus are large centric diatoms found in marine plankton. With ornate silica frustules, they can be abundant in productive waters and contribute substantially to marine primary production and silica cycling in ocean ecosystems.

Heliozoan
Actinophrys (sun animalcules) are spherical freshwater protists with radiating axopods used to capture prey. Their striking radial symmetry and hunting arms make them interesting microscopical subjects and important microscopic predators in aquatic microfauna.

Heterotrophic flagellate
Bodo saltans is a small heterotrophic flagellate that feeds on bacteria and detritus in freshwater and marine sediments. Common in microbial food webs, it’s used to study predator-prey interactions among microscopic planktonic organisms.

Silicoflagellate
Dictyocha is a silicoflagellate with an internal silica skeleton found in coastal and open oceans. Though not as famous as diatoms, silicoflagellates contribute to plankton diversity and can be important in certain bloom events and sediment records.

Blastocystis
Blastocystis is a common intestinal protist found in humans and many animals; its role in disease is debated. Detected in stool samples worldwide, it’s notable for genetic diversity between strains and for ongoing research into its health significance.

Karenia (red tide)
Karenia brevis is a marine dinoflagellate known for Florida red tides and production of potent neurotoxins affecting fish, marine mammals, and humans. Its blooms cause respiratory irritation, shellfish closures, and highlight the ecological impact of harmful algal species.

Mixotrophic chrysophyte
Mallomonas are small golden-brown flagellates with siliceous scales common in freshwater plankton. Many are mixotrophic, combining photosynthesis and predation on bacteria, and their scales preserve in sediments useful for environmental reconstructions.

Choanoflagellate colony
Some choanoflagellates form colonies resembling simple multicellularity and use flagella and collars to capture bacteria. Found in marine and freshwater habitats, they’re key to studying early steps toward animal multicellularity and microbial food webs.

Apicomplexan (oyster parasite)
Perkinsus olseni infects molluscs and is known from aquaculture and wild shellfish. As an apicomplexan-like protist, it compromises host health, influences marine bivalve populations, and prompts monitoring in fisheries and conservation programs.

-green algal filament
Spirogyra is a filamentous green alga often seen as slimy green strands in ponds and ditches. Microscopic cell spiraled chloroplasts give it a distinctive look, and it’s an important producer in freshwater ecosystems and classic lab material.

Foraminiferal plankton
Globigerina bulloides is a planktonic foraminifer with a calcareous test, abundant in open oceans. Its fossilized shells record past ocean conditions, making it an important indicator species in paleoceanography and marine sediment studies.

